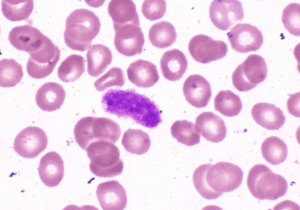
4-2.png 4-2.png
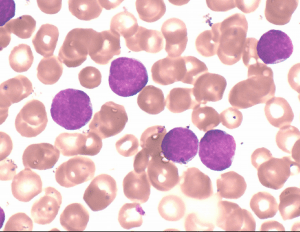
4-4.png 4-4.png

扎手指不哭的小男孩 ——如何利用血常规筛查白血病
我对面前这个三十初头的年轻妈妈说:“麻烦抱一下他,然后帮忙按着他的手”,这位母亲立刻说:“好的医生,放心,他很乖的”。
今年寒潮一波接一波,冷冰冰的空气冻得小男孩肉乎乎的脸蛋儿白里透红。小男孩今年四岁,圆圆的眼睛看起来很有灵气,他被妈妈包得厚厚实实,不吵不闹,一声不吭跟在妈妈后面。检查申请单上清楚地写着诊断,急性淋巴细胞白血病。哦,又是一个白血病的小孩。
儿童白血病是我国儿童发病率最高的恶性肿瘤,约占所有儿童恶性肿瘤的1/3。其中,儿童急性淋巴细胞白血病(ALL)是在儿童中最常见的白血病,约占儿童急性白血病的70%左右。实习以来,我确实也见到不少白血病儿童,尤其是和面前一样的急淋白血病儿童。

图1 急性淋巴细胞白血病
这位母亲抱着小男孩坐在椅子上,大手握着小手,在我准备扎手指的工具时,她不停地鼓励和夸奖:“他好乖的,刚刚医生也夸他听话呢”。小男孩不哭闹,也不乱动。因为小男孩的配合,我很顺利地完成了工作。这要是在抽血室,上演的就可都是“苦情大戏”,酒精擦拭到一半,弹簧针还没拿出来,小朋友常常就号啕大哭,小脸充血得红扑扑的。
扎完手指后,这位四岁的小男孩依旧没有落泪,安静乖巧地走出了诊室。我想他不是第一次经历同样的疼痛,他心里清楚自己的病情,也体谅父母的操劳和焦虑,所以小小年纪就会忍住不落泪。在血液科常常有成年人和我说,扎手指好疼,但也有很多小朋友都非常配合。曾经有一次,有个小朋友很害怕,从头到尾都在抑制恐惧的情绪,却直到我扎完手指处理好标本,他才走出诊室,放声大哭。所以我知道,这些小朋友不是不怕疼,是真的懂事。
来血液科扎手指的儿童,诊断常是急性淋巴细胞白血病。白血病细胞异常增殖会抑制正常造血功能,红细胞下降导致贫血,白细胞异常导致感染、发热,血小板下降导致出血等等。所以,也有相当一部分儿童是血常规指标异常来血液科查因的。
白血病患者的血常规指标中,红细胞和血红蛋白数量通常显示正细胞以及正素性贫血。网织红细胞数量常常会显示减少,但是少部分白血病患者的网织红细胞数量会出现轻微上升。若白血病患者处于早期阶段,血小板的数量可能会表现出正常或者轻微减少,等病情发展到中晚期,血小板数量会明显减少,甚至低于10×10⁹/L。血小板的形状大小不同,可能会出现畸形的情况,比如说巨型血小板。血小板第三因子和凝血功能也会出现异常情况。
图2 巨型血小板
白血病患者的白细胞数量会出现不同的情况。一般情况下,若白血病患者的白细胞数量较多,可能会达到300×10⁹/L,若白细胞数量比较少,可能只有0.2×10⁹/L。若检验人员是在血常规复检时即外周血涂片中,观察到原幼稚细胞,就算只有一个,对临床诊断都将起到关键的参考作用,医生再进行骨髓穿刺检查,若骨髓中原始细胞明显增高,这通常就是诊断急性白血病的主要依据。
图3 外周血中的原幼稚淋巴细胞

图4 骨髓中的原幼稚细胞
随着医疗技术的进步,临床检验手段越来越多样化,诊断白血病的方法也越来越多。而血常规检查仍然是白血病检查最基础也是最为重要的生化检验方法之一,在白血病的筛查过程中具有重要的价值意义。
不同类型的儿童白血病,预后各有不同。国内儿童急性淋巴细胞白血病的五年总体生存率目前也已达到70%,低危组可以达到85%。另外,儿童急性早幼粒细胞白血病生存率较好,五年生存率可达90%以上。总之,大家面对白血病不必谈“癌”色变,现在医疗手段愈加完善,部分型别白血病甚至可达到完全缓解;检验人员则应作好本职工作,把关好每一份检验报告的审核发送,为临床诊断、治疗等提供可靠信息;我由衷地希望每一个年纪尚小却能忍住疼痛的孩子,有温馨的童年和自由的未来。